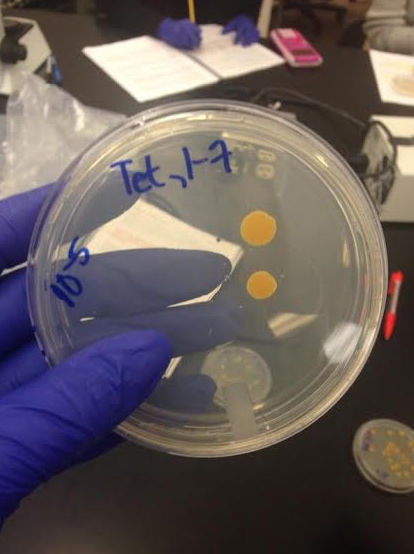
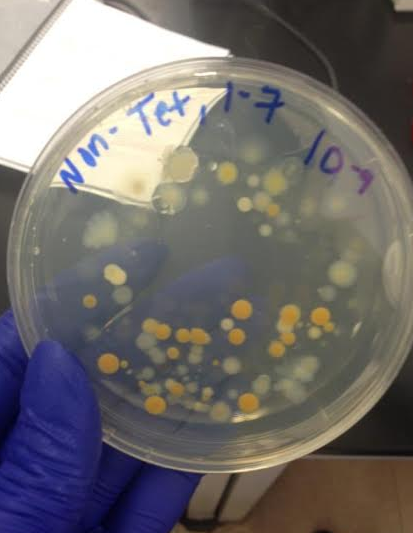

User:Ellery C. Spahr/Notebook/Biology 210 at AU
Effects of Fluoride on the Development of Zebrafish Seven Days Post-Fertilization - March 19, 2015
Purpose
This experiment studied the effects of fluoride on zebrafish larvae. At four days post-fertilization, zebrafish larvae have the ability to actively forage for food and avoid predation. By days five through seven, most zebrafish exhaust a majority of the embryonic yolk. These larvae develop visual and motor networks rapidly, in order to capture food and obtain necessary nutrients. This experiment examines zebrafish seven days post-fertilization. The zebrafish studied, therefore, developed a majority of the features necessary for survival. Researchers then examined if the fluoride effects development. Given past studies on embryonic development in humans and zebrafish, researchers predict no morphological changes 7 days post-fertilization.
Researches initially started with 20 zebrafish larvae. 10 of these larvae grew in a control petri dish (water) and 10 grew in an experimental petri dish (20 mL of fluoride solution).
Key terms
• Embryology: Describes how the embryo of a species develops post-fertilization (series of stages)
• Growth: Non-reversible increase in size of the organism
• Differentiation: Based on structure and function of a group of cells
• Morphogenesis: Development of pattern, shape, and form
Materials and Methods
Researchers first read other literature on the fluoride and its effects on fluoride. This provided a foundation for the formulation of a hypothesis. Initially, researchers predicted decreased size in the experimental group, in comparison to the control group. First, researchers transferred 20 mL of Deer Park water to a petri dish and 20 mL of fluoride solution to a petri dish. Then, researchers selected 20 healthy translucent embryos for the control dish and 20 for the experimental dish. Researchers used a dropper to transfer the eggs from the a container with water to the test dishes.
Friday, February 20 Twenty four hours following the transfer to control and experimental dishes, researchers removed any dead eggs. Unfortunately, due to human error, the eggs did not survive this first day. Researchers then selected an additional 40 eggs for the test dishes.
Monday, February 23 At four days, researchers removed 10mL of solution and added 25 mL. Then, observed a depression slide to note the length, movement and other features of the zebrafish.
Thursday, February 26 At 7 days, the researchers added one drop of food (paramecium) to both dishes. Then, researchers observed the zebrafish with the compound microscope and placed a few drops of a sample with the organisms in a depression slide at the 4x objective. Researchers transferred one larvae from the control and 3 from the experimental to a tube, and then added a drop of tricaine solution per milliliter of the water. This preserved the fish, allowing researchers to study characteristics at a later date.
Monday, March 2 At 11 days, researchers fed the remaining zebrafish (one paramecium in the control and one paramecium in the experimental), and observed the remaining zebrafish on a depression slide at the 4x objective.
Friday, March 6 At 14 days, researchers studied the zebrafish for
Data and Observations
Due to both human error and chance, researchers did not observe zebrafish larvae for the first six days post-fertilization. The data and observations of zebrafish, therefore, begin at 7 days post-fertilization.
Thursday, February 26 Zebrafish become larvae the seventh day post-fertilization. At this stage, researchers observed a fin and protruding mouth. Larvae appeared between 4 and 5 milliliters in total body length.
Monday, March 2 The control dish contained 9 viable zebrafish and the experimental dish contained 3 viable zebrafish. The zebrafish did not appear to differ significantly in size; overall, those in the control dish measured an estimated 5 to 7 milliliters and those in the experimental dish measured 5 to 6 milliliters. In terms of color, the zebrafish appeared green with a black spinal cord. At 11 days post-fertilzation, the dorsal fin appeared fully grown and spinal cord appeared fully formed. Overall, researchers noted no differences in morphology.
Thursday, March 6 At 14 days post-fertilization, the zebrafish larvae died.
Conclusions
This experiment examines zebrafish seven days post-fertilization. The zebrafish studied, therefore, developed a majority of the features necessary for survival. Given past studies on embryonic development in humans and zebrafish, researchers predicted no morphological changes 7 days post-fertilization and older. More zebrafish survived in the control than in the fluoride solution; however, had the researchers placed zebrafish one to three days post-fertilization in the fluoride, the results may differ dramatically. Perhaps no zebrafish would survive or the surviving zebrafish would exhibit major morphological differences. Morphologically, the surviving zebrafish in the control and experimental dishes did not differ significantly. Overall, this experiment encountered a great deal of human error; the dishes, both control and experimental, leaked and led to the death of embryos midway through the experiment. Moreover, researchers observed the zebrafish every three days. The data, as a result, did not note daily morphological changes. In the future, researchers may observe fish 7 days post-fertilization and establish a clearer time table for the development of certain features. Though most organs and body structures develop by this stage, teeth continue to develop. With more time and access to resources, researchers may establish a link between teeth development and fluoride exposure.
Analyzing the Final Product of the 16s Sequence - March 5, 2015
Purpose
This experiment characterized bacteria from the Hay Infusion cultures; it studied one bacteria colony from the nutrient agar plates and one bacteria colony from the tetracycline plates. DNA sequencing and encrypting confirmed the type of bacteria in the sample. Equipped with an understanding of which bacteria inhabit the transect, researchers may further analyze the relationships between bacteria and other organisms.
Materials and Methods
This experiment further analyzed data from a previous laboratory (January 29). First, I transferred bacteria from the two plates (nutrient agar and tetracycline) into a tube containing 100 microliters of water. I then incubated the tubes for 10 minutes in a heating block, at 100 degrees Celsius. Following this, I placed the samples in a centrifuge for 5 minutes. I placed twenty microliters of the primer into a PCR tube, while the samples centrifuged. Then, I gently shook the tube until the PCR bead dissolved. Lastly, I placed 5 microliters from the centrifuged samples into the PCR tubes. The following week, I examined the products of the PCR reaction in aragose gel and observed the DNA ladder. Bacteria sequencing confirmed a code for each bacteria. The "blast" website encrypted the codes and provided a specific DNA sequence.
Data and Observations
Conclusion
The results indicate the "Marsh" contains a gram-negative, rod-shaped Pseudomonas bacteria. Overall, the motility, colony morphology, gram staining and arrangement match with previous studies of the bacteria. Though a number of observed characteristics matched the characteristics of Pseudomonas, the size and shape do not align. This likely occurred from human error. Yet, I would consider the experiment an overall success because researchers correctly identified a wide range of organisms, and successfully used this information to study the symbiotic relationships within the transect.
Vertebrates and Niches - February 15, 2015
Purpose
This report concludes the series of experiments on the “Marsh” transect. In the course of six weeks, I examined bacteria, protists, fungi, plants and invertebrates living in the transect. This experiment offered insight into presence and function of vertebrates, which inhabit or pass through the transect. As the final component in the food chain, vertebrates likely have symbiotic relationships with organisms identified in previous experiments.
Materials and Methods
The procedure corresponds closely with previous experiments. For an estimated 30 minutes, I observed and recorded the presence of vertebrate organisms in the transect. I observed it the niche midday, from 12:00 to 12:30. The temperature fell between 20 and 25 degrees Fahrenheit.
Data and Observations
I observed and classified five vertebrate species in the “Marsh” transect.
• Eastern Fox Squirrel (Phylum Cordata, Sciurus Niger) appeared to be chasing the Grey Squirrel
• Grey Squirrel (Sciurus Carolinesis) appeared to be chasing the Eastern Fox Squirrel
• Eastern Chipmunk (Genus Tamias, Tamias Striatus) appeared on a large rock covered with moss
• Bald Eagle (Genus Haliaeetus, Order Accipitriformes, Haliaeetus Leuciceorialis) flew over the transect, most likely to searching for food to prey on
• Song Sparrow (Family – Emberizdae, Genus – Melospiza melodia) appeared on the ground near short grass and a collection of rocks
The vertebrate and invertebrate species form symbiotic relationships with abiotic and biotic components, and benefit from the diversity within the niche. For instance, the song sparrow used leaves, branches, soil, grass and rocks to construct a nest. This nest will likely store food and protect its offspring from prey. The bird continuously flew to and from the nest, to supplement it with more abiotic and biotic components. The two squirrels appeared to be well camouflaged by the many plants. Yet, a majority of the plants appear brown at at this time of the year. In the spring, rising temperatures would lead to more color within the niche and the squirrels would receive less protection. The chipmunk also benefited from the plants in the transect. Initially, it rested along the moss-covered rock. However, when it noticed a potential threat, it ran between the tall cat tails for coverage.
The Bald Eagle, at the top of the food chain, represents level one. Level one generally contains carnivores. Level two contains vertebrates who either depend on vegetation or arthropods for energy. Level three subsequently branches into the plants on the surface and invertebrate microarthropods living in the soil. Lastly, level four represents the bacteria identified in the soil and on the surface of the leaves.
These organisms represent the ecological concept of community, because every organisms contributes to the success of the ecosystem as a whole. The vertebrates, invertebrates, plants and bacteria develop relationships (symbiotic, mutualistic, parasitic) and contribute to the food chain. The organisms collectively contribute to the ecosystem of the community and as a result, changes in one species effects all. Carrying capacity refers to the number of living organisms a niche supports without environmental degradation. Trophic levels, which refers to what an organism eats and what eats it, may be effected when a certain species evolves and becomes more successful or when a species becomes threatened and its populations declines. This subsequently affects every other organism in the niche.
...
Invertebrates - January 15, 2015
Purpose
This experiment studied and identified the invertebrate species from the Burlese Funnel, and ultimately: helped differentiate common soil invertebrates, understand the role of these organisms in the ecosystem and offer insight into the evolution of invertebrate species.
Materials and Methods (Procedure I: Acoelomates, Pseudocoelomates and Coelomates)
• Dissecting scope
• Wet mount with stain (to show the digestive tract of the organism)
Initially, I observed the movement of the acoelomate, Planaria with the dissecting scope. I subsequently observed and identified the movement of nematodes and cross sectional slide of the pseudocoelomate.
Materials and Methods (Procedure II: Arthropods)
This procedure differentiated the classes and orders of arthropods. I observed and classified the example organisms as arachnida, diplopoda, chilopoda, insect or crustacea. These five major classes differ by number of body parts, body segments, and appendages.
Materials and Methods (Procedure III: Analyzing the Invertebrates Collected by the Berlese Funnel)
• Petri dish
• Dissecting microscope
• Diagram to identify the species (Figure 3)
In the previous week, I collected leaf litter and placed it in a Burlese Funnel underneath ultraviolet light. This drives invertebrate species into an ethanol solution, and acted as a preservative for later observation. First, I deconstructed the Berlese Funnel and gently poured an estimated 10 to 15 mL from the ethanol solution. I then poured the remaining liquid into a second dish. I examined both layers of liquid with a dissecting microscope. Overall, I identified five invertebrate species.
Data and Observations (Procedure I)
• Acoelomate worms swim by cilia, ad appear to have rhythmical muscle spasms
• Nematodes appear to move side to side, but not crawl or life. Overall, it appears to thrash aimlessly rather than move with purpose. This may occur because the muscles align longitudinally.
• Coelomates have a well-defined muscular system, and therefore move by muscle contractions
Data and Observations (Procedure II)
1 - Insect
2 - Diploda
3 - Crustacea
4 - Arachnida
5 - Chilopoda
Data and Observations (Procedure III)
Table 1 - Soil Invertebrates from the "Marsh"
Figure 3 - Common Soil Invertebrates
Conclusions and Future Directions
The transect sample contained four common soil invertebrates. Perhaps, in the future, I would collect a sample of leaf litter from a different section of the transect or a different season. Certain species may not be as capable of surviving and reproducing in cold weather, and would therefore be more prevalent in warmer seasons. Greater diversity may exist, but the conditions do not appear to be most conducive.
Plantae and Fungi on February 12, 2015
Purpose
This experiment focused on collecting and examining the diversity of plant and fungi species in our transect (the “Marsh”). I proceeded to identify as many species as possible, based on size, shape, vascularization, specialized structures, and the mechanisms of reproduction. This experiment offers insight into the importance of plants and fungi in the ecosystem. In preparation for the next experiment, I also collected leaves and soil to examine the presence of invertebrates in the transect.
Materials and Methods (Procedure I: Collecting Five Plant Samples)
• Three Ziploc bags
• 500 grams of leaf litter (top layer of soft soil, dead leaves)
• Five plant samples
I collected five plant samples from the transect. In the laboratory, I first recorded the size and shape of each plant. I then examined the plants for vascularization, determining the size of the overall plant and the presence of vascular bundles. To determine mechanisms for reproduction, I examined the number of cotyledon, the shape of the leaf (long and narrow, or broad), the veins (parallel or network), the arrangement of vascular bundles (scattered or in a ring), and the floral parts (multiples of 3 or multiples of 4 to 5). I then recorded these observations in Figure (1).
Materials and Methods (Procedure VI: Berlese Funnel to Collect Invertebrates)
• Berlese funnel
• Light fixture
• Funnel
• Screening material
• 50 mL conical tube
• 25 mL of 50:50 ethanol and water solution
First, I poured 25 mL of the 50:50 ethanol and water solution into the 50 mL conical tube. I then fit a piece of the screening material into the lower portion of the funnel. To secure this screen, I taped the sides. This prevents leaves and soil from falling into the preservative (ethanol and water solution). Next, I carefully placed the leaf litter sample in the top of the funnel. I secured the funnel on a ring stand, holding the tube of ethanol. To prevent the ethanol from evaporating, I parafilmed the base of the funnel and the tube. Lastly, I placed a lighted 40 watt lamp above the funnel with an incandescent bulb 1 to 2 inches from the top of the leaf littler. I covered the entire sample in foil. The Berlese funnel will in place for one week, and will be examined next laboratory invertebrates.
Data and Observations
Plant Sample - 1
Plant Sample - 2
Plant Sample - 3
Plant Sample - 4
Plant Sample - 5
Conclusions and Future Directions
This experiment examined the diversity of plants in the "Marsh" transect. Overall, three plants would be classified as monocot and two classified as dicot; in addition, every plant structure contained vascular structures. Identifying these plants helps understand which organisms live int eh ecosystem. Plants offer support and resources to a number of organisms, and therefore benefit from symbiotic relationships. Next week, the Berlese Funnel will provide additional information on the invertebrates living alongside the plants studied.
Microbiology and Identifying Bacteria with DNA Sequences - February 4, 2015
Purpose
This experiment focused on identifying bacteria from the Hay Infusion Culture of the “Marsh” transect. The culture smells very strong and pungent. A majority of the water appeared to have evaporated. The moss disintegrated, and plant matter floated to the surface of the culture. I predict more moss and other plant matter will disintegrate every week.
In a prior experiment, I diluted samples from the Hay Infusion, and placed these samples on four nutrient agar plates and four tetracycline plates.
Most prokaryotes in the Domain Bacteria may not survive on these tetracycline plates; however, those from the Domain Archaea may survive, because these organisms survive in extreme climates. In addition, a few organisms from Domain Bacteria may survive because of natural selection. That is, this bacteria developed a resistance to tetracycline and subsequently survive on those plates.
Materials and Methods (Procedure III: Bacteria Cell Morphology Observations)
• Four nutrient agar plates, containing 10-3 10-3 10-7and 10-9 dilutions
• Four tetracycline plates, containing 10-3 10-3 10-7and 10-9 dilutions
• Microscope, with 10x through 100x lenses
• A loop to scrape a portion of growth from the surface of the agar
• A Bunsen Burner, to sterilize the loop
• A dropper, to transfer water onto the slide for a wet mount
• Cover slip, for the wet mount but not the gram stain
• Staining tray
• Crystal violet
• Wash bottle filled with water
• Gram’s iodine mordant
• 95 percent alcohol
• Safranin stain
• Kimwipe, to blot excess water and stain
I first counted the number of colonies on the eight plates. I compared the growth on the nutrient plates with nutrient + tetracycline plates. I then proceeded to collect samples from two nutrient plates and two nutrient + tetracycline plates. To examine the bacteria from these plates, I produced wet mounts by: sterilizing a loop over a flame, scraping a small portion of the growth from the agar surface, placed the bacteria and a drop of water on the slide, and slipped a cover over it. I observed this wet mount with the 10x and 40x objective. Through this, I determined the motility, shape and arrangement of the bacteria.
To classify the bacteria as either gram positive or gram negative, used a gram stain. As with the wet mount, I sterilized a loop over the flame and transferred a small portion of the growth onto a slide. I then placed a drop of water onto the slide. However, I then passed the slide through the flame multiple times to heat fix the air dried slide. When the water evaporated, I placed the bacterial smear on the staining tray and covered it with crystal violet for one minute. Using a wash bottle, I rinsed the stain from the slide with water. I then covered the bacterial smear with Gram’s iodine mordant for one minute and subsequently rinsed the stain with water. To decolorize the smear, I covered it with 95 percent alcohol for 10 to 20 seconds. I rinsed gently with the wash bottle, allowing the solvent to flow colorlessly from the slide. Lastly, I covered the smear with safranin stain for 20 to 30 seconds and rinsed the stain with the wash bottle. To examine the gram stain with a microscope, I blotted the excess water with a kimwipe.
Materials and Methods (Procedure IV: PCR for 16S Sequencing)
• 100 ul of water
• Sterile tube
• Centrifuge
• 20 ul of primer and water mixture
• PCR bead
• PCR machine
In preparation for the next lab, I transferred one colony of bacteria to 100 ul of water in a sterile tube. I did this four times, one for each plate tested. I then incubated the solution at 100 degrees Celsius for ten minutes. Following this, I centrifuged the samples for 5 minutes at 13,400 rpm. I added 20 ul of the primer to a smaller PCR tube, and gently mixed the primer with the PCR bead. When this bead dissolved, I transferred 5 ul of supernatant from the centrifuged samples to the PCR tube. I placed these four tubes in the PCR machine.
Data and Observations
I observed a number of differences in the nutrient agar plates and the tetracycline plates. The non-tetracycline plates contained lawns or significantly more colonies than the tetracycline plates. In addition, the non-tetracycline plates appeared more diverse in color. In contrast, the tetracycline plates contained simply dark orange colonies.
Conclusions and Future Directions
Overall, the tetracycline prevented the growth of bacteria. The dark orange bacteria, however, appeared to be the exception. On the nutrient agar plates, less dark orange bacteria appeared because it needed to compete with other bacteria. On the nutrient and tetracycline plates, though, this bacteria did not need to compete and grew into larger colonies. This bacteria may be insensitive to the antibiotic or antibiotic resistant. Tetracycline tends to prohibits protein synthesis, and subsequently kill certain bacteria. The following experiment relies on PCR to identify which bacteria tetracycline affected. PCR amplifies the DNA for identification, and gel electrophoresis helps specifically identify the bacteria.
Observing and Identifying Unicellular Eukarya
January 29, 2015
Purpose This experiment focused on the studying and identifying unicellular eukaryotes. A dichotomous key differentiated the microorganisms at the surface of the Hay Infusion Culture and from those near plant matter. Every small region of the culture differs in abiotic and biotic features. The experiment, therefore, tested two inter-samples from moss and from the surface of the culture. This reveals which organisms thrive in which environments. When examining samples from Hay Infusion Culture, more microorganisms will live near the plant matter than the surface of the culture.
Materials and Methods • Microscope (ranging from 10x to 40x) • Dichotomous key (a series of morphological choices based on observations of color, shape, length and movement) • Hay Infusion Culture (consisting of soil, plant matter, Deer Park water, and .1 gram of dried milk) • Protoslo (slowed the moving microorganisms, allowing for better focus and identification) • Nutrient agar plates and tetracycline plates • Test tubes • Ethanol and Bunsen Burner (to sterilize the spreader) • Micropipette (to transfer a 100 mL of the Hay Infusion culture to the tubes, and then to the nutrient agar and tetracycline plates)
First, I retrieved samples from the Hay Infusion Culture and placed a few drops on slide for a wet mount. I retrieved on sample from the surface of the culture, and the other from the surface of moss. A drop of Protoslo slowed the motile organisms. The microscope then magnified the microorganisms, which allowed for a thorough examination of color, shape, length and movement. I recorded these observations, and used the dichotomous key to identify organisms.
Then, in preparation for the next experiment, I prepared and plated serial dilutions of the Hay Infusion culture. With the lid on, I gently shook the container to mix the contents. I labeled four test tubes of 10 mL of sterile broth as 102, 104, 106 and 108; I also labeled four nutrient agar plates and four tetracycline plates with 102, 104, 106 and 108 on the agar side of the plate. To differentiate, I labeled the tetracycline plates with “tetra.” I used a micropipette to transfer a 100 mL from the Hay Infusion culture to the 102 tube, and swirled. I subsequently transferred a 100 mL from the 102 tube to the 104 tube, and repeated the process twice more to dilute the 106 and 108 tubes. I pipetted 100 mL of the dilutions onto the corresponding agar nutrient and tetracycline plates. Then, I removed the spreader from the ethanol bath, and then placed it in the flame. Before spreading the dilution on the plate, I allowed the flame to cool. When the dilutions spread across the respective plates, I placed the plates onto a rack to incubate a room temperature for a week. This process prepared the class to examine bacteria species in the culture.
Data The culture appeared light brown, with a distinctive darker brown growth on the surface of the culture and the side of the glass. Green and brown growth appeared on the moss at the bottom of the glass.
Surface
Paramecium Caudatum • Motile • 180 to 300 micrometers • Protist
Colpidium • Motile • 50 to 70 micrometers • Protist
Bursaria Truncatella • Motile • 500 to 1000 micrometers • Protist
Near Plant Matter
Vorticella • Motile • 50 to 75 micrometers • Protist
Paramecium Aurella • Motile • 120 to 180 micrometers • Protist
Chlamydomonas • Motile • 5 to 12 micrometers • Algae
Chlamydomonas can be characterized as form of isogamous, unicellular, motile algae. Chlamydomonas meets the requirements of life because: It replicates through asexual reproduction, when two cells function as isogametes. Composed of cells, it contains chloroplasts that allow it to photosynthesize and acquire energy. Scientists consider it the origin of multicellular evolution in the Volvocine line.
Conclusions and Future Directions Different species grow in different niches of the culture. More oxygen exists at the surface, and perhaps the microorganisms at the surface require more oxygen. In the future, more unicellular eukaryotes would likely reproduce.
E.S.
Observations of the "Marsh" at American University January 25, 2014
Purpose This experiment observed and tested a 20 by 20 meter transect at American University. Inspecting this niche offers insight into the abiotic and biotic components, which may have symbiotic or competitive relationships.
Materials and Methods First, I examined the assigned transect for thirty minutes. This transect sits approximately 30 feet from the Kogod School of Business, and 50 feet from the Massachusetts Avenue. Through the course of this examination, I drew a topographical arial map [attached]. I then collected 50 mL of soil and plant matter. An estimated 50 percent of the collection contained soil and 50 percent plant matter, such as moss and grass. During this collection, the temperature in Washington, D.C. fell between 35 and 40 degrees Celsius.
In preparation for the next lab, I prepared the Hay Infusion Culture. First, I measured 10 to 12 grams of soil and vegetation from the "Marsh," as well as 0.1 grams of dried milk. I then added this sample to 500 milliliters of Deer Park water, and gently shook the jar for ten seconds. I removed the top of the jar, and allowed organisms to grow in the culture for a week.
Data and Observations The transect appeared to be on relatively level ground. Tall stalks, sedimentary rocks, dry bushes, and grass cover a majority of the transect. The man-made elements were not immediately apparent but upon further inspection, I located a metal grate and a plaque. The transect contained other abiotic (non-breathing components), such as the sedimentary rocks, the soil, plastic and snow. However, the transect also featured a number of biotic (live) components such as bushes, grass, moss, stalks of wheat, and insects in the soil.
Conclusions and Future Directions I will periodically monitor the transect, to examine any changes in the niche. As the weather warms, I predict a rise in biotic organisms. This may be an increase in wildlife, such as squirrels or more insects.
E.S.
January 21, 2014
Current (extant) organisms originated from a single ancestor, which evolved and diverged from natural selection.
E.S.